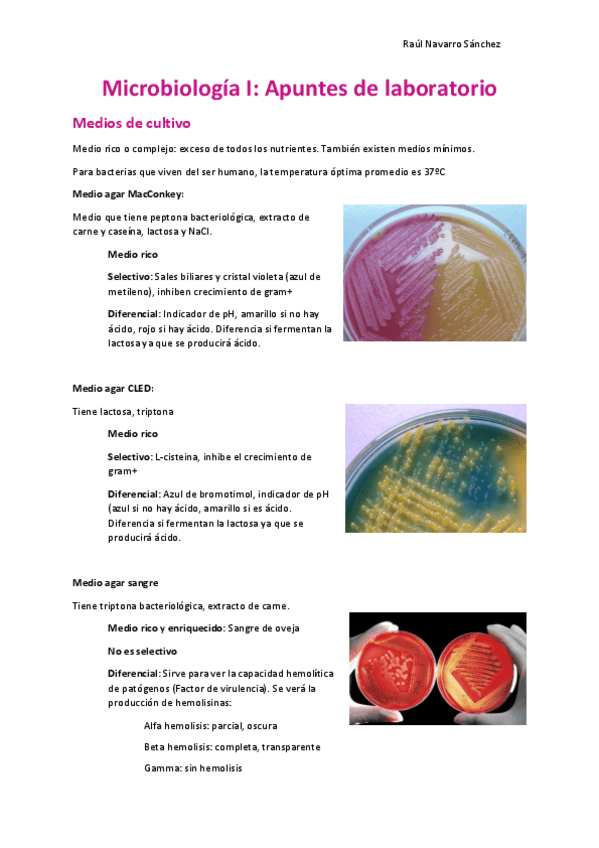

Microbiología I
He publicado nuevos apuntes de 2º Microbiología I: INTRODUCCION-A-LA-MICROBIOLOGIA.pdf
*opinas = resultado de la condensación entre aa y un cetoácido. Se metaliza por la planta y sirve a la bacteria com sustrato
Faltan algunas anotaciones: Sustrato de S.Mutans --> glucosa degradada x sobrios. En el tracto respiratorio la esterilización se consigue gracias al flujo de moco, celulas citadas y macrofagos alveolares. La cistitis tb la puede causar E.Coli
He publicado nuevos apuntes de 2º Microbiología I: esquemes-T5-micro.pdf
He publicado nuevos apuntes de 2º Microbiología I: esquemes-T2-micro.pdf
apuntes
-
Micro i
He publicado nuevos apuntes de 2º Microbiología I: Micro i
He publicado nuevos apuntes de 2º Microbiología I: GuionpracticaMICROBIOTEC1718.pdf
He publicado nuevos apuntes de 2º Microbiología I: Halosdeinhibicionantibioticos.jpg
apuntes
-
Microbiologia 1 (apuntes)
He publicado nuevos apuntes de 2º Microbiología I: Microbiologia 1 (apuntes)
apuntes
-
Apunts MCI (Temes 1-8)
He publicado nuevos apuntes de 2º Microbiología I: Apunts MCI (Temes 1-8)
apuntes
-
Microbiologia I
He publicado nuevos apuntes de 2º Microbiología I: Microbiologia I
He publicado nuevos apuntes de 2º Microbiología I: Apuntes-laboratorio.pdf
apuntes
-
Apuntes Micro I
He publicado nuevos apuntes de 2º Microbiología I: Apuntes Micro I

¡Estás al día!
Has visto todos los archivos